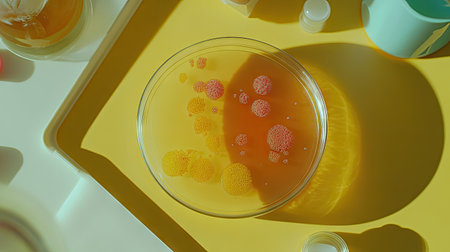
Overhead view of Petri dish on lab table, showing multiple colored colonies of bacteria on agar, a striking look at microbial diversity.の素材

素材 - Overhead view of Petri dish on lab table, showing multiple colored colonies of bacteria on agar, a striking look at microbial diversity.
作品情報
Overhead view of Petri dish on lab table, showing multiple colored colonies of bacteria on agar, a striking look at microbial diversity.
- ID:259086846
- 作品種別:
- 作者名:suphauarrn Manosri
キーワード
- background
- bacterium
- biochemistry
- biotechnology
- chemical
- chemistry
- clean
- clinic
- closeup
- development
- dish
- dripping
- dropper
- equipment
- examining
- experiment
- female
- fluid
- glasses
- glassware
- glove
- grey
- hand
- health
- industry
- instrument
- job
- laboratory
- liquid
- marble
- medication
- medicine
- microbiology
- person
- pharmacy
- pipette
- research
- science
- scientific
- scientist
- solution
- table
- test
- tool
- transparent
- treatment
- virus
- woman
- work
類似作品
Top view backgr...
Petri dish with...
Dessert bowl wi...
A petri dish wi...
Background with...
top view petri ...
Bacterial colon...
Close-up view o...
Close-up of a s...
A top-down macr...
Petri dish on o...
Abstract labora...
The hand holds ...
Abstract labora...
Out focus bood ...
subsensitivity ...
Spring flower o...
Microbial Art
Petri dish with...
Petri dish and ...
A close-up of p...
Close up petri ...
top view of a p...
colorful array ...
Abstract labora...
This striking i...
photo of fungi ...
top view of whi...
Backgrounds of ...
A petri dish wi...
Generative AI
Top view of a p...
Hands holding a...
A Colorful repr...
isolated on a b...
Clear glass pla...
microbial cultu...
Colorful microb...
Backgrounds of ...
A glass bowl fi...
Top view of pet...
Overhead view o...
Research of vir...
Petri dish cont...
Colorful petri ...
Petri dishes wi...
Close-up of a p...
This image feat...
Pink bacteria c...